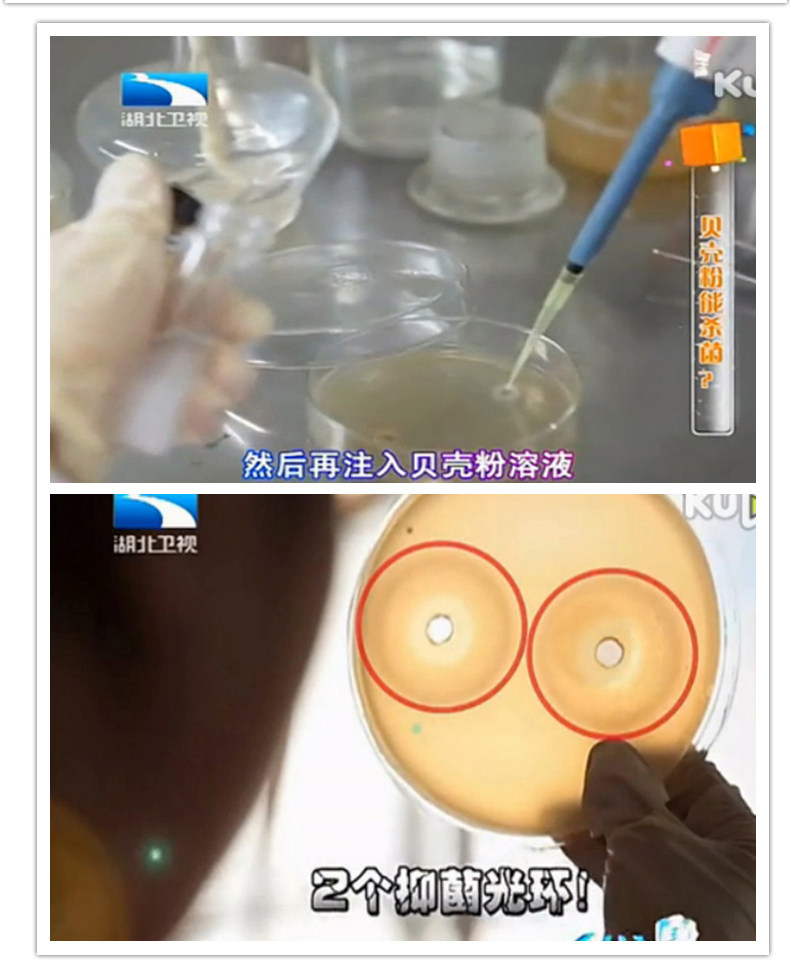

Япония импортированный порошок оболочки, фрукты, овощи и дикие овощи, мыть фрукты чистящие средства для удаления пестицидов 90 г × 1 бутылка

Цена: 1 055руб. (¥49.9)
Артикул: 542928528557
Вес товара: ~0.7 кг. Указан усредненный вес, который может отличаться от фактического. Не включен в цену, оплачивается при получении.
Описание товараPHA+PHAgc3R5bGU9InRleHQtYWxpZ246IGxlZnQ7Ij48YSBocmVmPSJodHRwczovL3BhZ2VzLnRtYWxsLmNvbS93b3cvYW4vY3MvYWN0L3d1cHI/d2hfYml6PXRtJndoX3BpZD1hY3QlMkYxNzY0NzBkMmE0MCZkaXNhYmxlTmF2PVlFUyIgdGFyZ2V0PSJfYmxhbmsiPjxpbWcgc3JjPSJodHRwczovL2ltZy5hbGljZG4uY29tL2ltZ2V4dHJhL2kzLzIyMDA4MDQ1OTk2NjEvTzFDTjAxQzNOMHdEMkxFbjJyZ2h4Y1NfISEyMjAwODA0NTk5NjYxLTAtc2NtaXRlbTYwMDAuanBnIiBhbGlnbj0iYWJzbWlkZGxlIj48L2E+PC9wPjxwIHN0eWxlPSJ0ZXh0LWFsaWduOiBsZWZ0OyI+PGEgaHJlZj0iaHR0cHM6Ly9wYWdlcy50bWFsbC5jb20vd293L2Fyay1wdWIvY29tbW9uL2VlMzBjNTBhL3RwbD93aF9zaWQ9OWQ3NWI0ZjA1NTUxODIxMSZtY0JyYW5kQ2FyZD10cnVlIiB0YXJnZXQ9Il9ibGFuayI+PGltZyBzcmM9Imh0dHBzOi8vaW1nLmFsaWNkbi5jb20vaW1nZXh0cmEvaTIvMjIwMDgwNDU5OTY2MS9PMUNOMDFWZlhuZ2kyTEVuMXNkZDJNel8hITIyMDA4MDQ1OTk2NjEtMC1zY21pdGVtNjAwMC5qcGciIGFsaWduPSJhYnNtaWRkbGUiPjwvYT48L3A+PHAgc3R5bGU9InRleHQtYWxpZ246IGxlZnQ7Ij48YSBocmVmPSJodHRwczovL3BhZ2VzLnRtYWxsLmNvbS93b3cvYXJrLXB1Yi9jb21tb24vZWUzMGM1MGEvdHBsP3doX3NpZD1hMzg1NzBjZjhhZTA1NjYyJm1jQnJhbmRDYXJkPXRydWUiIHRhcmdldD0iX2JsYW5rIj48aW1nIHNyYz0iaHR0cHM6Ly9pbWcuYWxpY2RuLmNvbS9pbWdleHRyYS9pMy8yMjAwODA0NTk5NjYxL08xQ04wMWg5SjY1TDJMRW4xUzU2SnlsXyEhMjIwMDgwNDU5OTY2MS0wLXNjbWl0ZW02MDAwLmpwZyIgYWxpZ249ImFic21pZGRsZSI+PC9hPjwvcD48cCBzdHlsZT0idGV4dC1hbGlnbjogbGVmdDsiPjxhIGhyZWY9Imh0dHBzOi8vY2hhb3NoaS5kZXRhaWwudG1hbGwuY29tL2l0ZW0uaHRtP3NwbT1hMzIwNC43OTMzMjYzLjAuMC40OTMyNzgxOHpKREs1dyZpZD02MDc5OTUxMTE1MTUmcmV3Y2F0aWQ9NTA1MTQwMDgiIHRhcmdldD0iX2JsYW5rIj48aW1nIHNyYz0iaHR0cHM6Ly9pbWcuYWxpY2RuLmNvbS9pbWdleHRyYS9pMi8yMjAwODA0NTk5NjYxL08xQ04wMUxNV1FHTDJMRW4xUDhwQUFuXyEhMjIwMDgwNDU5OTY2MS0wLXNjbWl0ZW02MDAwLmpwZyIgYWxpZ249ImFic21pZGRsZSI+PC9hPjxhIGhyZWY9Imh0dHBzOi8vY2hhb3NoaS5kZXRhaWwudG1hbGwuY29tL2l0ZW0uaHRtP3NwbT1hMzIwNC43OTMzMjYzLjAuMC40OTMyNzgxOHpKREs1dyZpZD01Njg2MDYzMjM3NTUmcmV3Y2F0aWQ9NTA1MTQwMDgiIHRhcmdldD0iX2JsYW5rIj48aW1nIHNyYz0iaHR0cHM6Ly9pbWcuYWxpY2RuLmNvbS9pbWdleHRyYS9pNC8yMjAwODA0NTk5NjYxL08xQ04wMVRCb29OczJMRW4xU3dya1J4XyEhMjIwMDgwNDU5OTY2MS0wLXNjbWl0ZW02MDAwLmpwZyIgYWxpZ249ImFic21pZGRsZSI+PC9hPjxhIGhyZWY9Imh0dHBzOi8vY2hhb3NoaS5kZXRhaWwudG1hbGwuY29tL2l0ZW0uaHRtP3NwbT1hMzIwNC43OTMzMjYzLjAuMC4yMWIzMzVlYllLYlRyaSZpZD01NjEzOTU0ODU0OTcmcmV3Y2F0aWQ9NTA1MTQwMDgiIHRhcmdldD0iX2JsYW5rIj48aW1nIHNyYz0iaHR0cHM6Ly9pbWcuYWxpY2RuLmNvbS9pbWdleHRyYS9pMi8yMjAwODA0NTk5NjYxL08xQ04wMVViQks1SzJMRW4xUHo0TFJHXyEhMjIwMDgwNDU5OTY2MS0wLXNjbWl0ZW02MDAwLmpwZyIgYWxpZ249ImFic21pZGRsZSI+PC9hPjxhIGhyZWY9Imh0dHBzOi8vY2hhb3NoaS5kZXRhaWwudG1hbGwuY29tL2l0ZW0uaHRtP3NwbT1hMzIwNC43OTMzMjYzLjAuMC4yYjJlNWJhZmphYkEzNSZpZD02MTQ4MDI1ODIzMTMmcmV3Y2F0aWQ9NTA1MTQwMDgiIHRhcmdldD0iX2JsYW5rIj48aW1nIHNyYz0iaHR0cHM6Ly9pbWcuYWxpY2RuLmNvbS9pbWdleHRyYS9pMS8yMjAwODA0NTk5NjYxL08xQ04wMTdvSm1DTTJMRW4xTjdRZjBlXyEhMjIwMDgwNDU5OTY2MS0wLXNjbWl0ZW02MDAwLmpwZyIgYWxpZ249ImFic21pZGRsZSI+PC9hPjwvcD48cCBzdHlsZT0idGV4dC1hbGlnbjogbGVmdDsiPjxhIGhyZWY9Imh0dHBzOi8vY2hhb3NoaS5kZXRhaWwudG1hbGwuY29tL2l0ZW0uaHRtP3NwbT1hMzIwNC43OTMzMjYzLjAuMC4zYTRlNGY1YmJWYWhCZyZpZD02MTI3OTk0NTI4ODkmcmV3Y2F0aWQ9NTA1MTQwMDgiIHRhcmdldD0iX2JsYW5rIj48aW1nIHNyYz0iaHR0cHM6Ly9pbWcuYWxpY2RuLmNvbS9pbWdleHRyYS9pMi8yMjAwODA0NTk5NjYxL08xQ04wMWtwaWRNYTJMRW4xT3NUbTdGXyEhMjIwMDgwNDU5OTY2MS0wLXNjbWl0ZW02MDAwLmpwZyIgYWxpZ249ImFic21pZGRsZSI+PC9hPjxhIGhyZWY9Imh0dHBzOi8vY2hhb3NoaS5kZXRhaWwudG1hbGwuY29tL2l0ZW0uaHRtP3NwbT1hMzIwNC43OTMzMjYzLjAuMC40NTFjNGMxNm9CR3UybSZpZD01NTY2MDI1MzIxNTUmcmV3Y2F0aWQ9NTA1MTQwMDgiIHRhcmdldD0iX2JsYW5rIj48aW1nIHNyYz0iaHR0cHM6Ly9pbWcuYWxpY2RuLmNvbS9pbWdleHRyYS9pMS8yMjAwODA0NTk5NjYxL08xQ04wMVRTeW9zQjJMRW4xR3RtQ3VvXyEhMjIwMDgwNDU5OTY2MS0wLXNjbWl0ZW02MDAwLmpwZyIgYWxpZ249ImFic21pZGRsZSI+PGltZyBzcmM9Imh0dHBzOi8vaW1nLmFsaWNkbi5jb20vaW1nZXh0cmEvaTMvMjIwMDgwNDU5OTY2MS9PMUNOMDE1UW96QnYyTEVuMU43UnMxNF8hITIyMDA4MDQ1OTk2NjEtMC1zY21pdGVtNjAwMC5qcGciIGFsaWduPSJhYnNtaWRkbGUiPjwvYT48YSBocmVmPSJodHRwczovL2NoYW9zaGkuZGV0YWlsLnRtYWxsLmNvbS9pdGVtLmh0bT9zcG09YTMyMDQuNzkzMzI2My4wLjAuNDc4YTQzZWFYZnkwY2smaWQ9NjE1MzQ0NDk4NjEyJnJld2NhdGlkPTUwNTE0MDA4IiB0YXJnZXQ9Il9ibGFuayI+PGltZyBzcmM9Imh0dHBzOi8vaW1nLmFsaWNkbi5jb20vaW1nZXh0cmEvaTMvMjIwMDgwNDU5OTY2MS9PMUNOMDF0TGpkdk4yTEVuMVI0bjRLVV8hITIyMDA4MDQ1OTk2NjEtMC1zY21pdGVtNjAwMC5qcGciIGFsaWduPSJhYnNtaWRkbGUiPjwvYT48YnI+PGltZyBzcmM9Imh0dHBzOi8vaW1nLmFsaWNkbi5jb20vaW1nZXh0cmEvaTQvMjIwMDgwNDU5OTY2MS9PMUNOMDFSMHZJR2kyTEVuMVBFeHAxWV8hITIyMDA4MDQ1OTk2NjEtMC1zY21pdGVtNjAwMC5qcGciIGFsaWduPSJhYnNtaWRkbGUiIHN0eWxlPSJ0ZXh0LWFsaWduOiBjZW50ZXI7Ij48YnI+PGltZyBzcmM9Imh0dHBzOi8vaW1nLmFsaWNkbi5jb20vaW1nZXh0cmEvaTMvMjIwMDgwNDU5OTY2MS9PMUNOMDFxT1NhVlQyTEVuMVB5ak9pel8hITIyMDA4MDQ1OTk2NjEtMC1zY21pdGVtNjAwMC5qcGciIGFsaWduPSJhYnNtaWRkbGUiPjxhIGhyZWY9Imh0dHBzOi8vbGlzdC50bWFsbC5jb20vL3NlYXJjaF9wcm9kdWN0Lmh0bT9xPSVDOCVENSVCNyVFNyZ1c2VyX2lkPTcyNTY3Nzk5NCZ0eXBlPXAmY2F0PTUwNTE0MDA4JnNwbT1hMzIwNC43OTMzMjYzLmEyMjI3b2guZDEwMCZmcm9tPWNoYW9zaGkuLnBjXzFfc2VhcmNoYnV0dG9uIiB0YXJnZXQ9Il9ibGFuayI+PGltZyBzcmM9Imh0dHBzOi8vaW1nLmFsaWNkbi5jb20vaW1nZXh0cmEvaTEvMjIwMDgwNDU5OTY2MS9PMUNOMDFZeGlGTUwyTEVuMVI0T3BlRl8hITIyMDA4MDQ1OTk2NjEtMC1zY21pdGVtNjAwMC5qcGciIGFsaWduPSJhYnNtaWRkbGUiPjwvYT48YSBocmVmPSJodHRwczovL2xpc3QudG1hbGwuY29tLy9zZWFyY2hfcHJvZHVjdC5odG0/cT1ub3ZvcGluJnVzZXJfaWQ9NzI1Njc3OTk0JnR5cGU9cCZjYXQ9NTA1MTQwMDgmc3BtPWEzMjA0Ljc5MzMyNjMuYTIyMjdvaC5kMTAwJmZyb209Y2hhb3NoaS4ucGNfMV9zZWFyY2hidXR0b24iIHRhcmdldD0iX2JsYW5rIj48aW1nIHNyYz0iaHR0cHM6Ly9pbWcuYWxpY2RuLmNvbS9pbWdleHRyYS9pNC8yMjAwODA0NTk5NjYxL08xQ04wMTRwaFlHZDJMRW4xU3djeWxtXyEhMjIwMDgwNDU5OTY2MS0wLXNjbWl0ZW02MDAwLmpwZyIgYWxpZ249ImFic21pZGRsZSI+PC9hPjxhIGhyZWY9Imh0dHBzOi8vbGlzdC50bWFsbC5jb20vc2VhcmNoX3Byb2R1Y3QuaHRtP3E9JUQzJUEyJUM2JUQ1JUMxJUQ2JUNBJUNGJnVzZXJfaWQ9NzI1Njc3OTk0JnR5cGU9cCZjYXQ9NTA1MTQwMDgmc3BtPTEuMS5hMjIyN29oLmQxMDAmZnJvbT1jaGFvc2hpLi5wY18xX3NlYXJjaGJ1dHRvbiIgdGFyZ2V0PSJfYmxhbmsiPjxpbWcgc3JjPSJodHRwczovL2ltZy5hbGljZG4uY29tL2ltZ2V4dHJhL2kzLzIyMDA4MDQ1OTk2NjEvTzFDTjAxUmtlc1I1MkxFbjFPc0NyN1RfISEyMjAwODA0NTk5NjYxLTAtc2NtaXRlbTYwMDAuanBnIiBhbGlnbj0iYWJzbWlkZGxlIj48L2E+PC9wPjxwIHN0eWxlPSJ0ZXh0LWFsaWduOiBsZWZ0OyI+PGEgaHJlZj0iaHR0cHM6Ly9saXN0LnRtYWxsLmNvbS8vc2VhcmNoX3Byb2R1Y3QuaHRtP3E9ZG9tb2wmdXNlcl9pZD03MjU2Nzc5OTQmdHlwZT1wJmNhdD01MDUxNDAwOCZzcG09YTMyMDQuNzkzMzI2My5hMjIyN29oLmQxMDAmZnJvbT1jaGFvc2hpLi5wY18xX3NlYXJjaGJ1dHRvbiIgdGFyZ2V0PSJfYmxhbmsiPjxpbWcgc3JjPSJodHRwczovL2ltZy5hbGljZG4uY29tL2ltZ2V4dHJhL2kyLzIyMDA4MDQ1OTk2NjEvTzFDTjAxWGxtWElwMkxFbjFTd2ZuajRfISEyMjAwODA0NTk5NjYxLTAtc2NtaXRlbTYwMDAuanBnIiBhbGlnbj0iYWJzbWlkZGxlIj48L2E+PGEgaHJlZj0iaHR0cHM6Ly9saXN0LnRtYWxsLmNvbS8vc2VhcmNoX3Byb2R1Y3QuaHRtP3E9bW9ybmluZytmcmVzaCZ1c2VyX2lkPTcyNTY3Nzk5NCZ0eXBlPXAmY2F0PTUwNTE0MDA4JnNwbT1hMzIwNC43OTMzMjYzLmEyMjI3b2guZDEwMCZ4bD1tb3JuaW5nXzEmZnJvbT1jaGFvc2hpLi5wY18xX3N1Z2dlc3QiIHRhcmdldD0iX2JsYW5rIj48aW1nIHNyYz0iaHR0cHM6Ly9pbWcuYWxpY2RuLmNvbS9pbWdleHRyYS9pMy8yMjAwODA0NTk5NjYxL08xQ04wMUJKdk9pSjJMRW4xVW5ORHVXXyEhMjIwMDgwNDU5OTY2MS0wLXNjbWl0ZW02MDAwLmpwZyIgYWxpZ249ImFic21pZGRsZSI+PC9hPjxhIGhyZWY9Imh0dHBzOi8vbGlzdC50bWFsbC5jb20vL3NlYXJjaF9wcm9kdWN0Lmh0bT9xPSVCRCVFMCVCMCVENyVDRCVGNSZ1c2VyX2lkPTcyNTY3Nzk5NCZ0eXBlPXAmY2F0PTUwNTE0MDA4JnNwbT1hMzIwNC43OTMzMjYzLmEyMjI3b2guZDEwMCZmcm9tPWNoYW9zaGkuLnBjXzFfc2VhcmNoYnV0dG9uIiB0YXJnZXQ9Il9ibGFuayI+PGltZyBzcmM9Imh0dHBzOi8vaW1nLmFsaWNkbi5jb20vaW1nZXh0cmEvaTIvMjIwMDgwNDU5OTY2MS9PMUNOMDFScFJSYVAyTEVuMVA4bGJSd18hITIyMDA4MDQ1OTk2NjEtMC1zY21pdGVtNjAwMC5qcGciIGFsaWduPSJhYnNtaWRkbGUiPjwvYT48YSBocmVmPSJodHRwczovL2xpc3QudG1hbGwuY29tLy9zZWFyY2hfcHJvZHVjdC5odG0/cT0lQzYlRDUlQzAlRDYlQzQlQjcmdXNlcl9pZD03MjU2Nzc5OTQmdHlwZT1wJmNhdD01MDUxNDAwOCZzcG09YTMyMDQuNzkzMzI2My5hMjIyN29oLmQxMDAmZnJvbT1jaGFvc2hpLi5wY18xX3NlYXJjaGJ1dHRvbiIgdGFyZ2V0PSJfYmxhbmsiPjxpbWcgc3JjPSJodHRwczovL2ltZy5hbGljZG4uY29tL2ltZ2V4dHJhL2kyLzIyMDA4MDQ1OTk2NjEvTzFDTjAxN0tPdXNLMkxFbjFHdGVRNjFfISEyMjAwODA0NTk5NjYxLTAtc2NtaXRlbTYwMDAuanBnIiBhbGlnbj0iYWJzbWlkZGxlIj48L2E+PC9wPjxwIHN0eWxlPSJ0ZXh0LWFsaWduOiBjZW50ZXI7Ij48aW1nIHNyYz0iaHR0cHM6Ly9pbWcuYWxpY2RuLmNvbS9pbWdleHRyYS9pMS8yMjAwODA0NTk5NjYxL08xQ04wMTI5QzZOdDJMRW4yd2FZT1RZXyEhMjIwMDgwNDU5OTY2MS0wLXNjbWl0ZW02MDAwLmpwZyIgYWxpZ249ImFic21pZGRsZSI+PC9wPjxwIHN0eWxlPSJ0ZXh0LWFsaWduOiBjZW50ZXI7Ij48aW1nIHNyYz0iaHR0cHM6Ly9pbWcuYWxpY2RuLmNvbS9pbWdleHRyYS9pMS8zNTk2NjQ0Mzk5L08xQ04wMWtManpkWjFpTW1sdmxaS0xTXyEhMzU5NjY0NDM5OS0wLXNjbWl0ZW02MDAwLmpwZyIgYWxpZ249ImFic21pZGRsZSIgc3R5bGU9ImNvbG9yOiAjNmM2YzZjO2ZvbnQtZmFtaWx5OiBzaW1oZWk7Zm9udC1zaXplOiAyNC4wcHg7Ij48aW1nIHNyYz0iaHR0cHM6Ly9pbWcuYWxpY2RuLmNvbS9pbWdleHRyYS9pNC8zNTk2NjQ0Mzk5L08xQ04wMW5LVUFtcTFpTW1sbnEyUWVzXyEhMzU5NjY0NDM5OS0wLXNjbWl0ZW02MDAwLmpwZyIgYWxpZ249ImFic21pZGRsZSIgc3R5bGU9ImNvbG9yOiAjNmM2YzZjO2ZvbnQtZmFtaWx5OiBzaW1oZWk7Zm9udC1zaXplOiAyNC4wcHg7Ij48aW1nIHNyYz0iaHR0cHM6Ly9pbWcuYWxpY2RuLmNvbS9pbWdleHRyYS9pNC8zNTk2NjQ0Mzk5L08xQ04wMW9pRmx5NTFpTW1sdVhHQ0htXyEhMzU5NjY0NDM5OS0wLXNjbWl0ZW02MDAwLmpwZyIgYWxpZ249ImFic21pZGRsZSIgc3R5bGU9ImNvbG9yOiAjNmM2YzZjO2ZvbnQtZmFtaWx5OiBzaW1oZWk7Zm9udC1zaXplOiAyNC4wcHg7Ij48aW1nIHNyYz0iaHR0cHM6Ly9pbWcuYWxpY2RuLmNvbS9pbWdleHRyYS9pMi8zNTk2NjQ0Mzk5L08xQ04wMXBjVFRGVzFpTW1sdGp4MkVsXyEhMzU5NjY0NDM5OS0wLXNjbWl0ZW02MDAwLmpwZyIgYWxpZ249ImFic21pZGRsZSIgc3R5bGU9ImNvbG9yOiAjNmM2YzZjO2ZvbnQtZmFtaWx5OiBzaW1oZWk7Zm9udC1zaXplOiAyNC4wcHg7Ij48aW1nIHNyYz0iaHR0cHM6Ly9pbWcuYWxpY2RuLmNvbS9pbWdleHRyYS9pMy8zNTk2NjQ0Mzk5L08xQ04wMVdBT2V5YzFpTW1sd0N5bTlQXyEhMzU5NjY0NDM5OS0wLXNjbWl0ZW02MDAwLmpwZyIgYWxpZ249ImFic21pZGRsZSIgc3R5bGU9ImNvbG9yOiAjNmM2YzZjO2ZvbnQtZmFtaWx5OiBzaW1oZWk7Zm9udC1zaXplOiAyNC4wcHg7Ij48aW1nIHNyYz0iaHR0cHM6Ly9pbWcuYWxpY2RuLmNvbS9pbWdleHRyYS9pMy8zNTk2NjQ0Mzk5L08xQ04wMXgxZ2daYTFpTW1sdUpOd3FDXyEhMzU5NjY0NDM5OS0wLXNjbWl0ZW02MDAwLmpwZyIgYWxpZ249ImFic21pZGRsZSIgc3R5bGU9ImNvbG9yOiAjNmM2YzZjO2ZvbnQtZmFtaWx5OiBzaW1oZWk7Zm9udC1zaXplOiAyNC4wcHg7Ij48aW1nIHNyYz0iaHR0cHM6Ly9pbWcuYWxpY2RuLmNvbS9pbWdleHRyYS9pMy8zNTk2NjQ0Mzk5L08xQ04wMTBUTUUwaDFpTW1sdGp4Vk1xXyEhMzU5NjY0NDM5OS0wLXNjbWl0ZW02MDAwLmpwZyIgYWxpZ249ImFic21pZGRsZSIgc3R5bGU9ImNvbG9yOiAjNmM2YzZjO2ZvbnQtZmFtaWx5OiBzaW1oZWk7Zm9udC1zaXplOiAyNC4wcHg7Ij48aW1nIHNyYz0iaHR0cHM6Ly9pbWcuYWxpY2RuLmNvbS9pbWdleHRyYS9pMS8zNTk2NjQ0Mzk5L08xQ04wMUgyaG45YjFpTW1sczhKdXkzXyEhMzU5NjY0NDM5OS0wLXNjbWl0ZW02MDAwLmpwZyIgYWxpZ249ImFic21pZGRsZSIgc3R5bGU9ImNvbG9yOiAjNmM2YzZjO2ZvbnQtZmFtaWx5OiBzaW1oZWk7Zm9udC1zaXplOiAyNC4wcHg7Ij48aW1nIHNyYz0iaHR0cHM6Ly9pbWcuYWxpY2RuLmNvbS9pbWdleHRyYS9pMy8zNTk2NjQ0Mzk5L08xQ04wMTd2WEpRSTFpTW1sdVhKOUdmXyEhMzU5NjY0NDM5OS0wLXNjbWl0ZW02MDAwLmpwZyIgYWxpZ249ImFic21pZGRsZSIgc3R5bGU9ImNvbG9yOiAjNmM2YzZjO2ZvbnQtZmFtaWx5OiBzaW1oZWk7Zm9udC1zaXplOiAyNC4wcHg7Ij48aW1nIHNyYz0iaHR0cHM6Ly9pbWcuYWxpY2RuLmNvbS9pbWdleHRyYS9pNC8zNTk2NjQ0Mzk5L08xQ04wMXlTcmo5RDFpTW1sdWxTdFY1XyEhMzU5NjY0NDM5OS0wLXNjbWl0ZW02MDAwLmpwZyIgYWxpZ249ImFic21pZGRsZSIgc3R5bGU9ImNvbG9yOiAjNmM2YzZjO2ZvbnQtZmFtaWx5OiBzaW1oZWk7Zm9udC1zaXplOiAyNC4wcHg7Ij48aW1nIHNyYz0iaHR0cHM6Ly9pbWcuYWxpY2RuLmNvbS9pbWdleHRyYS9pMS8zNTk2NjQ0Mzk5L08xQ04wMXcyNXJwNTFpTW1sd0N5Wml5XyEhMzU5NjY0NDM5OS0wLXNjbWl0ZW02MDAwLmpwZyIgYWxpZ249ImFic21pZGRsZSIgc3R5bGU9ImNvbG9yOiAjNmM2YzZjO2ZvbnQtZmFtaWx5OiBzaW1oZWk7Zm9udC1zaXplOiAyNC4wcHg7Ij48aW1nIHNyYz0iaHR0cHM6Ly9pbWcuYWxpY2RuLmNvbS9pbWdleHRyYS9pMS8zNTk2NjQ0Mzk5L08xQ04wMUZsUFZGMzFpTW1sdGp4UkZpXyEhMzU5NjY0NDM5OS0wLXNjbWl0ZW02MDAwLmpwZyIgYWxpZ249ImFic21pZGRsZSIgc3R5bGU9ImNvbG9yOiAjNmM2YzZjO2ZvbnQtZmFtaWx5OiBzaW1oZWk7Zm9udC1zaXplOiAyNC4wcHg7Ij48aW1nIHNyYz0iaHR0cHM6Ly9pbWcuYWxpY2RuLmNvbS9pbWdleHRyYS9pNC8zNTk2NjQ0Mzk5L08xQ04wMWtvNHdBODFpTW1sdU5CU2d4XyEhMzU5NjY0NDM5OS0wLXNjbWl0ZW02MDAwLmpwZyIgYWxpZ249ImFic21pZGRsZSIgc3R5bGU9ImNvbG9yOiAjNmM2YzZjO2ZvbnQtZmFtaWx5OiBzaW1oZWk7Zm9udC1zaXplOiAyNC4wcHg7Ij48aW1nIHNyYz0iaHR0cHM6Ly9pbWcuYWxpY2RuLmNvbS9pbWdleHRyYS9pMS8zNTk2NjQ0Mzk5L08xQ04wMWxETmx3RDFpTW1sdUoyd0JwXyEhMzU5NjY0NDM5OS0wLXNjbWl0ZW02MDAwLmpwZyIgYWxpZ249ImFic21pZGRsZSIgc3R5bGU9ImNvbG9yOiAjNmM2YzZjO2ZvbnQtZmFtaWx5OiBzaW1oZWk7Zm9udC1zaXplOiAyNC4wcHg7Ij48aW1nIHNyYz0iaHR0cHM6Ly9pbWcuYWxpY2RuLmNvbS9pbWdleHRyYS9pMS8zNTk2NjQ0Mzk5L08xQ04wMVJiWjM5ZjFpTW1sdUozR3puXyEhMzU5NjY0NDM5OS0wLXNjbWl0ZW02MDAwLmpwZyIgYWxpZ249ImFic21pZGRsZSIgc3R5bGU9ImNvbG9yOiAjNmM2YzZjO2ZvbnQtZmFtaWx5OiBzaW1oZWk7Zm9udC1zaXplOiAyNC4wcHg7Ij48aW1nIHNyYz0iaHR0cHM6Ly9pbWcuYWxpY2RuLmNvbS9pbWdleHRyYS9pMy8zNTk2NjQ0Mzk5L08xQ04wMUVvclh2ajFpTW1sdzF6VVMxXyEhMzU5NjY0NDM5OS0wLXNjbWl0ZW02MDAwLmpwZyIgYWxpZ249ImFic21pZGRsZSIgc3R5bGU9ImNvbG9yOiAjNmM2YzZjO2ZvbnQtZmFtaWx5OiBzaW1oZWk7Zm9udC1zaXplOiAyNC4wcHg7Ij48aW1nIHNyYz0iaHR0cHM6Ly9pbWcuYWxpY2RuLmNvbS9pbWdleHRyYS9pMy8zNTk2NjQ0Mzk5L08xQ04wMXdKcDdYVzFpTW1sdGp4cUZnXyEhMzU5NjY0NDM5OS0wLXNjbWl0ZW02MDAwLmpwZyIgYWxpZ249ImFic21pZGRsZSIgc3R5bGU9ImNvbG9yOiAjNmM2YzZjO2ZvbnQtZmFtaWx5OiBzaW1oZWk7Zm9udC1zaXplOiAyNC4wcHg7Ij48aW1nIHNyYz0iaHR0cHM6Ly9pbWcuYWxpY2RuLmNvbS9pbWdleHRyYS9pMi8zNTk2NjQ0Mzk5L08xQ04wMTVLblp1czFpTW1sdEFEQm5PXyEhMzU5NjY0NDM5OS0wLXNjbWl0ZW02MDAwLmpwZyIgYWxpZ249ImFic21pZGRsZSIgc3R5bGU9ImNvbG9yOiAjNmM2YzZjO2ZvbnQtZmFtaWx5OiBzaW1oZWk7Zm9udC1zaXplOiAyNC4wcHg7Ij48aW1nIHNyYz0iaHR0cHM6Ly9pbWcuYWxpY2RuLmNvbS9pbWdleHRyYS9pMi8zNTk2NjQ0Mzk5L08xQ04wMTFYMVNJMTFpTW1sdmxhQ1kxXyEhMzU5NjY0NDM5OS0wLXNjbWl0ZW02MDAwLmpwZyIgYWxpZ249ImFic21pZGRsZSIgc3R5bGU9ImNvbG9yOiAjNmM2YzZjO2ZvbnQtZmFtaWx5OiBzaW1oZWk7Zm9udC1zaXplOiAyNC4wcHg7Ij48aW1nIHNyYz0iaHR0cHM6Ly9pbWcuYWxpY2RuLmNvbS9pbWdleHRyYS9pMi8zNTk2NjQ0Mzk5L08xQ04wMVFIcXQ0MjFpTW1sdTV2U3FxXyEhMzU5NjY0NDM5OS0wLXNjbWl0ZW02MDAwLmpwZyIgYWxpZ249ImFic21pZGRsZSIgc3R5bGU9ImNvbG9yOiAjNmM2YzZjO2ZvbnQtZmFtaWx5OiBzaW1oZWk7Zm9udC1zaXplOiAyNC4wcHg7Ij48aW1nIHNyYz0iaHR0cHM6Ly9pbWcuYWxpY2RuLmNvbS9pbWdleHRyYS9pNC8zNTk2NjQ0Mzk5L08xQ04wMXRhMjljSjFpTW1sdVhMQTVXXyEhMzU5NjY0NDM5OS0wLXNjbWl0ZW02MDAwLmpwZyIgYWxpZ249ImFic21pZGRsZSIgc3R5bGU9ImNvbG9yOiAjNmM2YzZjO2ZvbnQtZmFtaWx5OiBzaW1oZWk7Zm9udC1zaXplOiAyNC4wcHg7Ij48aW1nIHNyYz0iaHR0cHM6Ly9pbWcuYWxpY2RuLmNvbS9pbWdleHRyYS9pNC8zNTk2NjQ0Mzk5L08xQ04wMW1zdzFkbTFpTW1sdVhKeEh3XyEhMzU5NjY0NDM5OS0wLXNjbWl0ZW02MDAwLmpwZyIgYWxpZ249ImFic21pZGRsZSIgc3R5bGU9ImNvbG9yOiAjNmM2YzZjO2ZvbnQtZmFtaWx5OiBzaW1oZWk7Zm9udC1zaXplOiAyNC4wcHg7Ij48aW1nIHNyYz0iaHR0cHM6Ly9pbWcuYWxpY2RuLmNvbS9pbWdleHRyYS9pMy8zNTk2NjQ0Mzk5L08xQ04wMTB5ZDFJNDFpTW1sdWxUQUZJXyEhMzU5NjY0NDM5OS0wLXNjbWl0ZW02MDAwLmpwZyIgYWxpZ249ImFic21pZGRsZSIgc3R5bGU9ImNvbG9yOiAjNmM2YzZjO2ZvbnQtZmFtaWx5OiBzaW1oZWk7Zm9udC1zaXplOiAyNC4wcHg7Ij48aW1nIHNyYz0iaHR0cHM6Ly9pbWcuYWxpY2RuLmNvbS9pbWdleHRyYS9pMi8zNTk2NjQ0Mzk5L08xQ04wMURIVEU5dTFpTW1sc2pHVG1mXyEhMzU5NjY0NDM5OS0wLXNjbWl0ZW02MDAwLmpwZyIgYWxpZ249ImFic21pZGRsZSIgc3R5bGU9ImNvbG9yOiAjNmM2YzZjO2ZvbnQtZmFtaWx5OiBzaW1oZWk7Zm9udC1zaXplOiAyNC4wcHg7Ij48L3A+PC9wPg==
Продавец:天猫超市
Рейтинг:

Всего отзывов:0
Положительных:0
Добавить в корзину